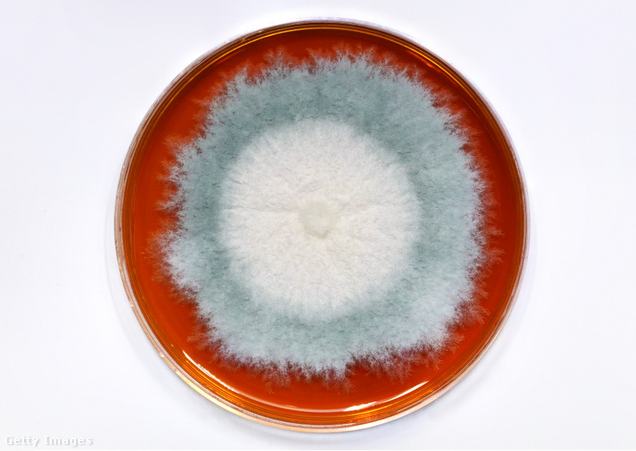

Akár nemzeti pánik is kitörhetne, ha Franciaországban bejelentenék a sajttermelők, hogy ők bizony nem tudnak több Brie vagy Camembert sajtot előállítani.
Ugyanis máig ott, Franciaországban van a termelési központja ezeknek az érlelt, krémes, általában igen erős ízű és szagú sajtoknak. Azonban a Brie és Camembert szerelmeseit hamarosan letargiába taszíthatja egy nem is olyan régi felfedezés: kihaló félben lehet e két sajtért felelős penészgomba.
A Brie sajt (de hasonlóan készül a Camembert is) elkészítése során a tejhez fermentálás után adják hozzá a penicillium camemberti nevű penészgombát, mely a megfelelő hőmérsékleten fehér takaróval vonja be a sajtot, így az az érlelés alatt felveszi végleges, puha, krémes állagát és jellegzetes édeskés ízt nyer.
Ehhez a kellemes ízű, és ehető penészfajtához hosszú évek kísérletezései vezettek, végül az 1800-as években talált rá egy francia kutató. A penicillium camembertit elsősorban fehér színe különböztette meg a többi sajtra alkalmazott kék penészgombától, és sokkal egészségesebbnek is mutatkozott ezeknél (az akkor használt kék penészgombák eltértek a mai kéksajtokéitól), így világszerte ez terjedt el a sajtpiacon. Máig kizárólag ezt a penészgombát használják a Brie és Camembert sajtok elkészítéséhez. Azonban a világszintű termelésnek, a túltenyésztésnek és az alternatíva hiányának komoly ára lehet.
Jeanne Ropars a French National Center of Scientific Research kutatója a Business Insidernek számolt be róla, mit fedeztek fel a laboratóriumban a penészgombáról:
![]()
A penicillium camemberti fajon belül nincsen genetikai diverzitás.
Genetikai zsákutca
A kutató azt is elmagyarázza, hogy ez miért jelenthet problémát a jövőben. A penésznek egy olyan genetikai mutációja alakult ki, mely során nem képes az önálló szaporodásra, így mesterségesen szaporítják, mondhatni klónozzák a későbbi felhasználáshoz, azonban ezzel a módszerrel egyre nehezebb az eredeti gombát lemásolni és ez egyre több mutációra ad lehetőséget.
Ez a jelenség előreláthatóan a sajtkészítők számára komoly problémákat okoz majd, hiszen ha a penészgombát nem tudják érdemben szaporítani, nekik sem marad elég a sajt nemesítéséhez, hiánycikk lesz a penicillium camemberti.
Fokozott veszélyeztetettség
Genetikai sokféleség nélkül a penész ráadásul a különböző betegségeknek sem tud érdemben ellenállni, így ezek is könnyedén elpusztíthatják. (Ahogyan erről a Business Insider videója is beszámol, hasonló történt a legnépszerűbb banánfajtával, a cavendish banánnal is, melyet sok éven át termesztettek egyféleképpen, most pedig egy halálos gomba hatalmas pusztítást tudott végezni a fajtán).
Nem csak a sajtokról van szó
Jeanne Ropars arra is figyelmeztet, ez a küzdelem nem csak a sajtról szól:
![]()
Ez túlmutat a penészen, az egész világon elveszítjük a biológiai sokféleséget
Nagyon nehéz új alternatívát találni, főleg a természetben található penészgombák között válogatva, mivel nagy részük mérgező. A kutatók folyamatosan vizsgálják a különböző penészfajtákat, hogy megtalálják a penicillin camemberti lehetséges helyettesítőjét, ám eddig sajnos még nem jártak sikerrel, így elképzelhető, hogy más alternatívát kell találnia majd a sajtkészítőknek.
Ebből a cikkből megtudhatod, honnan származik és hogyan készül a magyarok legendás sajtja.























